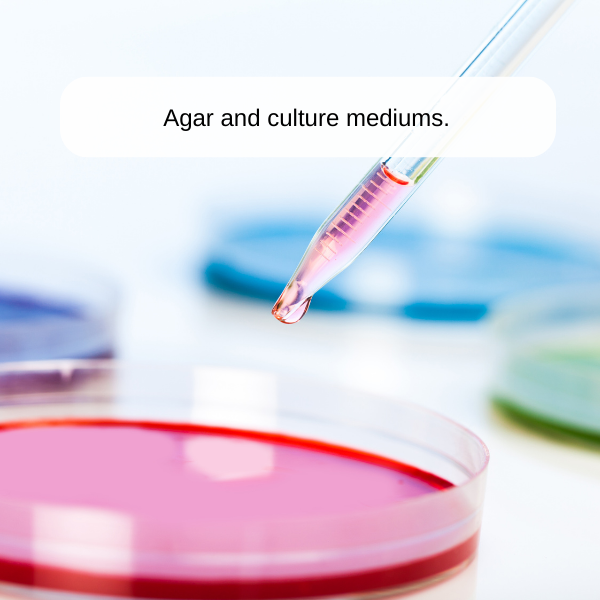

IcanClave 3242T 29L Laboratory Autoclave
Details
- "B " Class
- 29 Litre
- Laboratory autoclave
ICANCLAVE 3242T 29L Laboratory Autoclave
The 3242T laboratory autoclave was specifically designed for laboratory settings. These 29 litre benchtop sterilisers are used in pharmacies, universities, the food industry and across microbiology, material testing and biochemistry laboratories, to name a few.
The 3242T laboratory autoclave provides superior, accurate and safe sterilisation that can be fully verified and traced.
Features
- Class B autoclave provides the highest level of sterilisation of hollow and wrapped instruments.
- Additional sterilisation materials include porous, rubber, plastics, lab waste, culture mediums, glass, food and textiles.
- Sterilises up to 134 degrees Celsius for 0.5 – 99 minutes.
- Independent steam generator for efficient sterilisation.
- Pulsating vacuum system.
- Mechanical and electrical safety protection, and automatic door.
- Media temperature sensor.
- Separate dual tanks – fresh and waste water.
- Rapid drying phase.
- Fully automatic, pre-set and user-defined programs.
- Internal memory can save 1000 cycles plus USB and in-built printer.
- Easy to use and operate.
- Expertly designed and quality built.
Included
- Free validation (including validation report and certificate).
- Free installation.
- Parts and labour warranty – 2 years.
- 24/7 Australian-based phone support
- Access to affordable annual validations, services, and repairs.
- Staff training available.z
Application
B Class Sterilisation Wide Range of use from Medical, Dental, Podiatry, Beauty, Veterinary and Laboratory.
Safety, Monitoring, Tracing and Verification
- Dual in-built safety system protects the machine and user from a cycle starting if the door is not secured.
- If there is an electrical fault or short circuit, power is automatically cut.
- Pressure overloads in the steam generator or chamber are prevented by safety valves.
- Self-detection and identification of errors coupled with a unique error code.
- Maintenance alerts and warnings provided automatically.
- In-built memory, printer and USB ensure no cycle data is lost.
Quick Look at the 3242T 29L
Chamber Size: 320mm x 420mm
Overall Size: 640mm (wide) x 560mm (high) x 640mm (deep)
Maximum Loading Capacities: 12 x 250ml bottles / 9 x 500ml bottles / 6 x 1L bottles / 2 x 2L bottles
Voltage: 220v/110v
Watts (power): 2300w
Maximum sterilisation temperature: 134 ℃
Weight: 96kg (net)